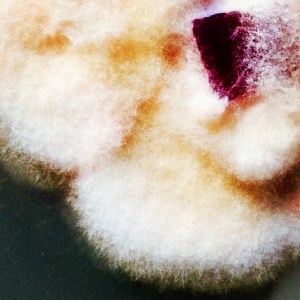
Ophiliocordyceps sinensis mycelium (Caterpillar Fungus)

July 9 – 12, 2025
Westfir | Oregon
4-Day Hands-On Course, with 2 Online Sessions
Food and Camping Included
Details below…
Join us to learn the practices and theories of working with Mushrooms and other Fungi to address toxic soils, filter water, enhance ecosystems, and empower communities.
Themes of the Week:
- Laboratory Introduction, Set-Up, and Advanced Skills
- Experimental Design Planning and Testing
- Introduction to Chemical and Heavy Metal Toxicity of Soil, Water, and the Human Body
- Sampling and Interpreting data for Soil and Water Quality testing
- Land Reading and Site History Development
- Grassroots Approaches and Industrial Remediation Methods
- Screening Fungi for Chemical Degradation Capabilities
- Building and Testing Mycelium Water Filtration Units
- Anti-Desertification and Heavy Metal Sequestration Techniques with Mycorrhizae
- Liquid Culture for BioDegredation
- Organic Pesticide Development with Fungi
- Ecological Restoration of Damaged Landscapes Partnering with Plants
- Case Histories of Land and Water Remediation projects
- Project Planning, Collaborative Approaches, and working with Municipalities
- Growing Restorative Fungi for Resilient Ecosystems
- Social and Community outreach and Impact
- Medicinal Mushrooms and Self Care
This workshop is organized as a facilitated working group, with every participant taking on a variety of roles as we work through projects throughout the week.

Course Instructor Ja Schindler is mushroom cultivator, gardener, writer, independent researcher,teacher, community organizer, environmental and food justice activist. Originally from Detroit, Michigan, his concerns in post-industrial urban renewal, food security, and environmental awareness developed into an affinity for bioremediation and fungi, now 18 years in development.
Ja is the founder and director of Fungi For The People, an educational organization with the mission to help build resilient and ecologically enhanced communities. Since 2010, more than 6,000 people from all over the world have joined their hands-on courses.
From his research lab, farm and mushroom homestead in Oregon, Ja is cultivating a diversity of projects to support citizen science and ecological restoration.

As part of the Mushroom Cultivation Design Center, he is producing cultivation supplies and mushroom extracts while maintaining a culture library of over 400 mushroom species. Other ongoing projects include developing an open-source mushroom spore bank; mycelium stormwater filtration research with Oregon municipalities; mycelium natural building projects; mushroom Food Forest designs; and progressing natural technologies.
Other Projects and Trainings:
- Princeton Groundwater Pollution and Hydrology Training
- University of Florida – Arbuscular Mycorrhizae Training



Learning Experience:
Our first two sessions will be online, once a week, for the two weeks leading up to the in-person course. These 2 hour online sessions will cover important introduction and theory. The four days of in-person classes are primarily hands-on and will be held in both indoor and outdoor spaces. MycoRemediation is a mix of clean and messy activities so we will be teaching in a variety of spaces including a professional laboratory, mushroom farm homestead, community garden, and indoor classroom.
Every process and activity is presented for you to engage with as much as you wish, with emphasis on helping you develop skills and understanding.
Course size is kept fairly small (15 people) to ensure that everyone can participate in every stage and be able to have any questions addressed. Typically we have guests who travel from all over the US and Canada, and frequently from as far away as Europe, Asia, Africa, and South America, so expect to learn a lot from the diversity of unique people who will also be joining. We will have a French and Spanish interpreter on staff for this course as well.
This Course Includes:
100+ Page Workbook: Details on a variety of techniques and vital course notes, glossary of terms, and technical references.
Open-Source research article collection: wide variety of relevant publication in print and digital forms.
Mushroom Cultures: You will get 6 species of edible, medicinal, and mycoremediation research fungi to leave with
Wholesome Meals: Lunch and Dinner will be provided daily, and is included in the price. Vegetarian and Gluten Free diets are accommodated for, and most of the food is sourced locally grown from small organic diversified farms, with Gourmet Mushrooms and Medicinal Mushroom Teas.
Free Tent Camping On-Site: Tent camping is encouraged on our 17-acre property here along the headwaters of the Middle Fork Willamette River here in Westfir, Oregon. A shared outdoor camp kitchen is available for your convenience, with bathroom and shower available for use.
Off-site Lodging: The course is located within short distance to a variety of accommodations in the Westfir / Oakridge area at your cost and arrangement. Prices range from $60 -$100+ per night and suggested links are included in the info packet that is emailed upon registration.
____________________________


Registration Information:
Course registration includes:
- All course Fees and Materials
- 2 online sessions and 4 days in-person
- Digital Research and Resource Pack
- Mushroom Starter Cultures
- 100+ Page Course Manual
- Lunch and Dinner
- Tent camping option on-site
Register Here:
Session closed. Check back for upcoming dates.
_________________________________
This course is designed to be an empowering introduction to Bioremediation with Fungi.
No prior training or experience is required, just an interest in remediation potentials of fungi and a willingness to learn.
_________________________________
For questions about this course please contact us here:
Leave a comment